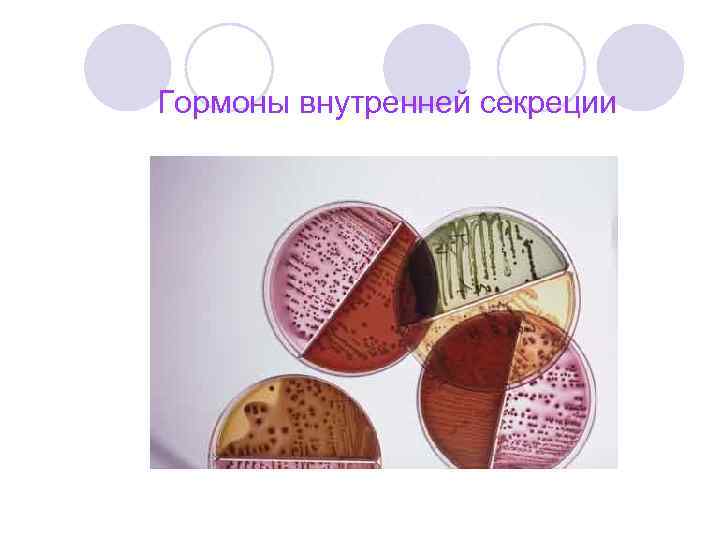
Гормоны внутренней секреции

Лекция 5. Эндокринный аппарат.ppt
- Количество слайдов: 28
 Эндокринный аппарат
Эндокринный аппарат
 Эндокринный аппарат — это совокупность желёз внутренней секреции, которые регулируют работу организма, обеспечивают рост и развитие, постоянство состава и свойств внутренней среды (гомеостаз) и приспособление организма (адаптацию) к меняющимся условиям внешней и внутренней среды с помощью различных гормонов.
Эндокринный аппарат — это совокупность желёз внутренней секреции, которые регулируют работу организма, обеспечивают рост и развитие, постоянство состава и свойств внутренней среды (гомеостаз) и приспособление организма (адаптацию) к меняющимся условиям внешней и внутренней среды с помощью различных гормонов.

 Действие эндокринного аппарата происходит посредством желёз внутренней секреции, которые выделяют гормоны, оказывающие огромное влияние на функционирование организма человека. Эндокринные железы (железы внутренней секреции) — железы и параганглии, синтезирующие гормоны, которые выделяются в кровеносные (венозные) или лимфатические капилляры. Эндокринные железы не имеют выводных протоков.
Действие эндокринного аппарата происходит посредством желёз внутренней секреции, которые выделяют гормоны, оказывающие огромное влияние на функционирование организма человека. Эндокринные железы (железы внутренней секреции) — железы и параганглии, синтезирующие гормоны, которые выделяются в кровеносные (венозные) или лимфатические капилляры. Эндокринные железы не имеют выводных протоков.
 Железы внутренней секреции: • Щитовидная железа • Паращитовидные железы • Вилочковая железа (тимус) • Надпочечники • Половые железы — яички и яичники • Инкреторная часть поджелудочной железы. • Гипоталамо-гипофизарная система (гипоталамус, гипофиз). • Эпифиз
Железы внутренней секреции: • Щитовидная железа • Паращитовидные железы • Вилочковая железа (тимус) • Надпочечники • Половые железы — яички и яичники • Инкреторная часть поджелудочной железы. • Гипоталамо-гипофизарная система (гипоталамус, гипофиз). • Эпифиз
 Щитовидная железа Щитови дная железа (лат. glandula thyr(e)oidea) — эндокринная железа у позвоночных, хранящая йод и вырабатывающая йодсодержащие гормоны (йодтиронины), участвующие в регуляции обмена веществ и росте отдельных клеток, а также организма в целом — тироксин (тетрайодтиронин, T 4) и трийодтиронин (T 3).
Щитовидная железа Щитови дная железа (лат. glandula thyr(e)oidea) — эндокринная железа у позвоночных, хранящая йод и вырабатывающая йодсодержащие гормоны (йодтиронины), участвующие в регуляции обмена веществ и росте отдельных клеток, а также организма в целом — тироксин (тетрайодтиронин, T 4) и трийодтиронин (T 3).
 Паращитовидные железы Паращитови дные же лезы (паратиреоидные железы, околощитовидные железы) — четыре небольших эндокринных железы, расположенные около щитовидной железы, попарно у её верхушки и основания. Две расположены справа от трахеи, две — слева. Вырабатывают паратиреоидный гормон, или паратгормон. Также паращитовидные железы вырабатываюткальцитонин.
Паращитовидные железы Паращитови дные же лезы (паратиреоидные железы, околощитовидные железы) — четыре небольших эндокринных железы, расположенные около щитовидной железы, попарно у её верхушки и основания. Две расположены справа от трахеи, две — слева. Вырабатывают паратиреоидный гормон, или паратгормон. Также паращитовидные железы вырабатываюткальцитонин.
 Щитовидная железа Паращитовидные железы
Щитовидная железа Паращитовидные железы
 Ткань щитовидной железы под микроскопом
Ткань щитовидной железы под микроскопом
 Вилочковая железа (тимус) Ти мус (ви лочковая железа) — орган лимфопоэза человека и многих видов животных, в котором происходит созревание, дифференцировка и иммунологическое «обучение» Tклеток иммунной системы.
Вилочковая железа (тимус) Ти мус (ви лочковая железа) — орган лимфопоэза человека и многих видов животных, в котором происходит созревание, дифференцировка и иммунологическое «обучение» Tклеток иммунной системы.
 Вилочковая железа (тимус)
Вилочковая железа (тимус)
 Надпочечники Надпо чечники — парные эндокринные железы позвоночных животных и человека. У человека расположены в непосредственной близости к верхнему полюсу каждой почки. Играют важную роль в регуляции обмена веществ и в адаптации организма к неблагоприятным условиям (реакция на стрессовые условия). Надпочечники состоят из двух структур — коркового вещества и мозгового вещества, которые регулируются нервной системой.
Надпочечники Надпо чечники — парные эндокринные железы позвоночных животных и человека. У человека расположены в непосредственной близости к верхнему полюсу каждой почки. Играют важную роль в регуляции обмена веществ и в адаптации организма к неблагоприятным условиям (реакция на стрессовые условия). Надпочечники состоят из двух структур — коркового вещества и мозгового вещества, которые регулируются нервной системой.
 Надпочечники
Надпочечники
 Половые железы • Мужские Яи чки, тести кулы (лат. testis, testiculus — свидетели (соития)) — парные мужские половые железы, в которых образуются мужские половые клетки (сперматозоиды) и стероидные гормоны, в основном тестостерон. Вообще у животных называется семенниками. Яичком принято называть обычно парную мужскую половую железу у млекопитающих, в частности человека.
Половые железы • Мужские Яи чки, тести кулы (лат. testis, testiculus — свидетели (соития)) — парные мужские половые железы, в которых образуются мужские половые клетки (сперматозоиды) и стероидные гормоны, в основном тестостерон. Вообще у животных называется семенниками. Яичком принято называть обычно парную мужскую половую железу у млекопитающих, в частности человека.
 Яички
Яички
 Половые железы • Женские Яи чники — парные женские половые железы, расположенные в полости малого таза. Выполняют генеративную функцию, то есть являются местом, где развиваются и созревают женские половые клетки, а также являются железами внутренней секреции и вырабатывают половые гормоны (эндокринная функция).
Половые железы • Женские Яи чники — парные женские половые железы, расположенные в полости малого таза. Выполняют генеративную функцию, то есть являются местом, где развиваются и созревают женские половые клетки, а также являются железами внутренней секреции и вырабатывают половые гормоны (эндокринная функция).
 Яичники
Яичники
 Поджелудочная железа Поджелу дочная железа (лат. pancreas, ПЖЖ) — орган пищеварительной системы позвоночных. У человека поджелудочная железа расположена забрюшинно, лежит позади желудка на задней брюшной стенке. Среди железистых отделов поджелудочной железы разбросаны панкреатические островки, insulae pancreaticae; больше всего их встречается в хвостовой части железы. Эти образования относятся к железам внутренней секреции.
Поджелудочная железа Поджелу дочная железа (лат. pancreas, ПЖЖ) — орган пищеварительной системы позвоночных. У человека поджелудочная железа расположена забрюшинно, лежит позади желудка на задней брюшной стенке. Среди железистых отделов поджелудочной железы разбросаны панкреатические островки, insulae pancreaticae; больше всего их встречается в хвостовой части железы. Эти образования относятся к железам внутренней секреции.
 Панреатические островки (поджелудочная железа)
Панреатические островки (поджелудочная железа)
 Гипоталамо-гипофизарная система — объединение структур гипофиза и гипоталамуса, выполняющее функции как нервной системы, так и эндокринной. Этот нейроэндокринный комплекс является примером того, насколько тесно связаны в организме млекопитающих нервный и гуморальный способы регуляции
Гипоталамо-гипофизарная система — объединение структур гипофиза и гипоталамуса, выполняющее функции как нервной системы, так и эндокринной. Этот нейроэндокринный комплекс является примером того, насколько тесно связаны в организме млекопитающих нервный и гуморальный способы регуляции
 Гипоталамо-гипофизарная система
Гипоталамо-гипофизарная система
 Эпифиз Эпифи з, или шишкови дное тело (corpus pineale, epiphysis cerebri) — небольшой орган, выполняющий эндокринную функцию, считающийся составной частью эндокринной системы; прикреплён поводками к обоим зрительным буграм промежуточного мозга. Непарное образование серовато-красного цвета, расположенное в центре мозга между полушариями в месте межталамического сращения.
Эпифиз Эпифи з, или шишкови дное тело (corpus pineale, epiphysis cerebri) — небольшой орган, выполняющий эндокринную функцию, считающийся составной частью эндокринной системы; прикреплён поводками к обоим зрительным буграм промежуточного мозга. Непарное образование серовато-красного цвета, расположенное в центре мозга между полушариями в месте межталамического сращения.
 Эпифиз
Эпифиз
 Гуморальная регуляция — один из эволюционно ранних механизмов регуляции процессов жизнедеятельности в организме, осуществляемый через жидкие среды организма (кровь, лимфу, тканевую жидкость) с помощью гормонов, выделяемых клетками, органами, тканями. У высокоразвитых животных и человека гуморальная регуляция подчинена нервной регуляции и составляет совместно с ней единую систему нейрогуморальной регуляции.
Гуморальная регуляция — один из эволюционно ранних механизмов регуляции процессов жизнедеятельности в организме, осуществляемый через жидкие среды организма (кровь, лимфу, тканевую жидкость) с помощью гормонов, выделяемых клетками, органами, тканями. У высокоразвитых животных и человека гуморальная регуляция подчинена нервной регуляции и составляет совместно с ней единую систему нейрогуморальной регуляции.
 Гормоны (от греч. hormao –двигаю, побуждаю) – специфические, физиологически активные вещества, вырабатываемые железами внутренней секреции. Они оказывают влияние на рост и развитие организма, на процессы полового созревания, участвуют в регуляции деятельности организма. Основные свойства гормонов: а) обладают специфичностью; б) активны, действуют в малых количествах; в) поступают в кровь постоянно; г) регулируют жизнедеятельность организма.
Гормоны (от греч. hormao –двигаю, побуждаю) – специфические, физиологически активные вещества, вырабатываемые железами внутренней секреции. Они оказывают влияние на рост и развитие организма, на процессы полового созревания, участвуют в регуляции деятельности организма. Основные свойства гормонов: а) обладают специфичностью; б) активны, действуют в малых количествах; в) поступают в кровь постоянно; г) регулируют жизнедеятельность организма.
Гормоны внутренней секреции
Гормоны внутренней секреции
 Вывод Функции эндокринной системы и её значение для организма • координирует работу всех органов и систем; • участвует в химических реакциях; • отвечает за стабильность всех процессов жизнедеятельности; • совместно с иммунной и нервной системами регулирует рост и развитие человека; • участвует в регулировании функционирования репродуктивной системы человека; • является одним из генераторов энергии в организме; • участвует в образовании эмоциональных реакций человека и в его психическом поведении.
Вывод Функции эндокринной системы и её значение для организма • координирует работу всех органов и систем; • участвует в химических реакциях; • отвечает за стабильность всех процессов жизнедеятельности; • совместно с иммунной и нервной системами регулирует рост и развитие человека; • участвует в регулировании функционирования репродуктивной системы человека; • является одним из генераторов энергии в организме; • участвует в образовании эмоциональных реакций человека и в его психическом поведении.
 Спасибо за внимание!
Спасибо за внимание!


